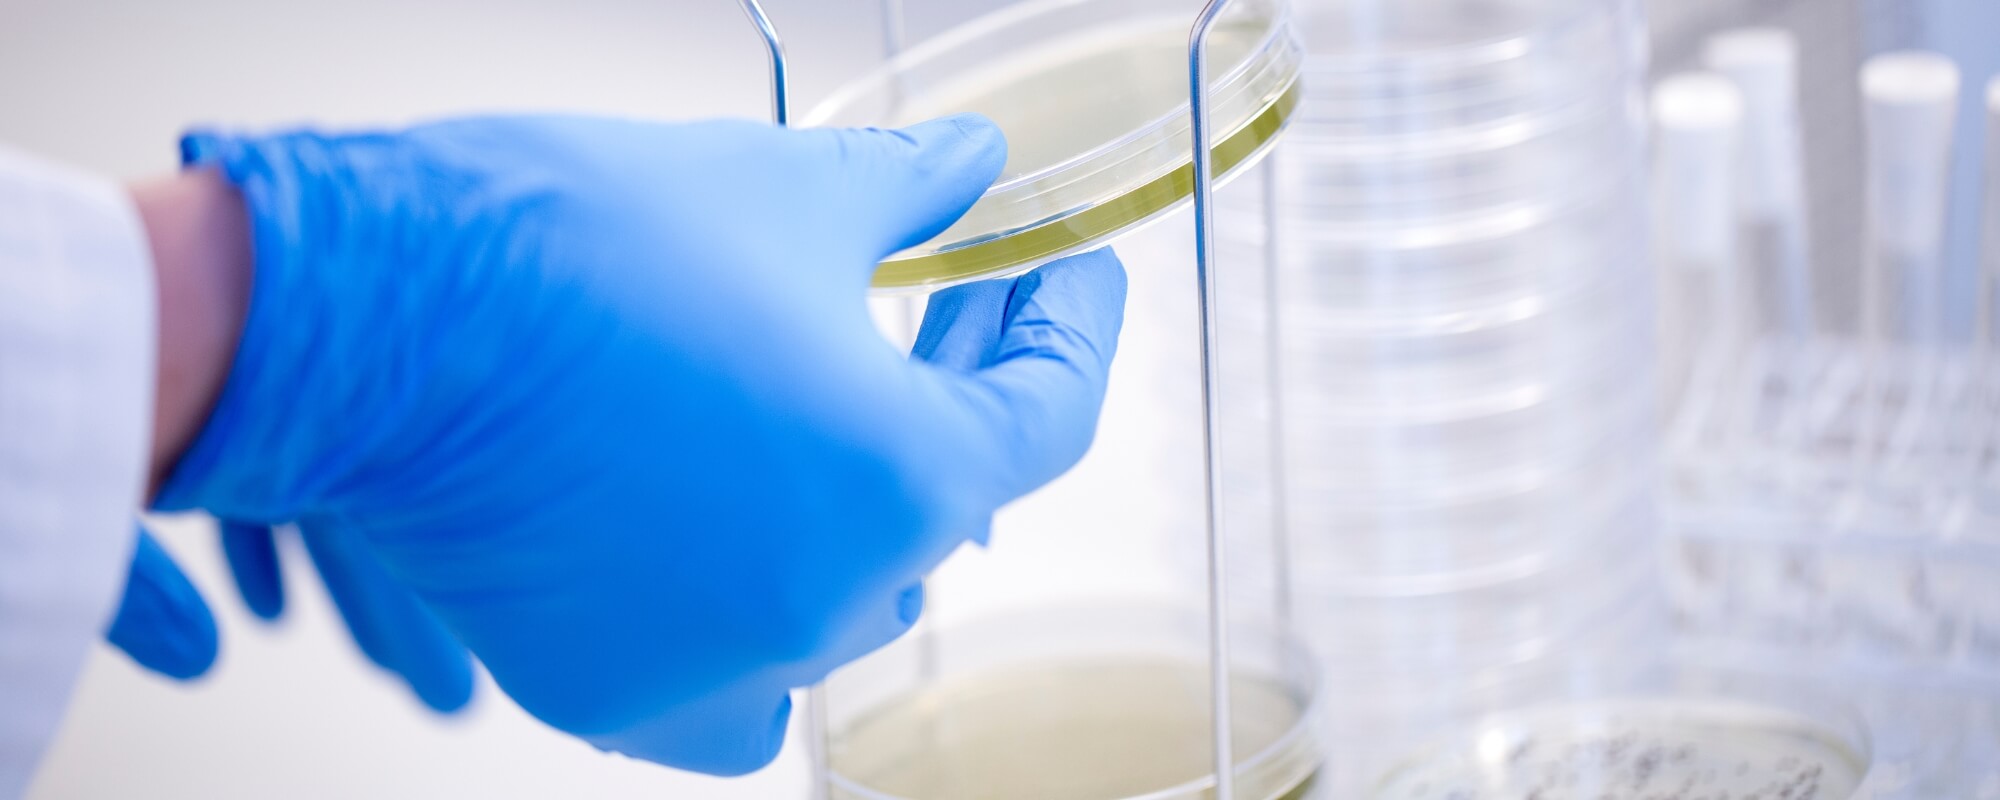

| Fragt | |||
| Total Moms |
|
||
| Total inkl. moms |
GUIDES
Få tips og tricks til at optimere arbejdet i laboratoriet og klinikken i Hounisens guides. Vi har samlet en række konkrete artikler, der hjælper dig med at vælge det rette udstyr til netop din arbejdsopgave.
Der er ingen artikler i denne kategori
- Sådan reducerer du hæmolyse
- Sådan forkorter du den totale ekspeditionstid (ToTAT)
- S-Monovette®: Opnå højeste standard for blodprøvetagning
- Optimal kvalitet med Multiply® PCR-plader
- Vælg Multiply® PCR-rør for de mest præcise resultater
- SARSTEDT mikrotestplader til immunologi
- Vælg objektglas efter din vævstype
- Kom godt i gang med ultralyd i din praksis
- Skånsomme blodprøver på dyr
- Sådan bruger du et stasebånd
- Tips til kapillær blodprøvetagning
Populære guides
.jpg)
Guides
Velkommen til Hounisens® webshop
Læs mere
Er det første gang, du besøger vores webshop, eller er du i tvivl om, hvordan du gennemfører en bestilling, kan du finde hjælp i vores guide herunder.


Guides
How to use Google Translate
Læs mere
For English-speaking users of our website: Use Google Translate to easily view translations of Danish texts on our webiste.


Guides
Få styr på mærkninger og certificeringer
Læs mere
På hounisen.com kan du finde en række mærkninger og certifikater, der fortæller om produkternes egenskaber, renhedsgrad eller særlige services, der tilbydes ved køb af pr...


Guides
Sådan finder du det rigtige rør
Læs mere
Har du problemer med at finde det rigtige rør? Prøv SARSTEDT Tube Finder, og få hurtigt svar på dine spørgsmål.


Guides
Hvad er LogMAR-synstavler?
Læs mere
Lær at forstå de grundlæggende principper bag en LogMAR-synstavle, og hvorfor det er vigtigt at bruge en standardiseret metode til pålidelige synstests.


Guides
Undgå skadelige formalindampe
Læs mere
Arbejd sikkert med vævsfiksering. Med det unikke lukkede formalinsystem kan du undgå at komme i kontakt med de sundhedsskadelige formalindampe.


Guides
Find den rette DURAN® flaske
Læs mere
DURAN® laboratorieflasker indgår i en omfattende produktportefølje, der bl.a. tæller DURAN® YOUTILITY, DURAN® PURE og DURAN® HPLC.

Guides
Sådan vælger du den rette handske
Læs mere
Det er vigtigt at vælge en godkendt handske, der overholder EU's krav, og som beskytter dig bedst muligt i den enkelte arbejdssituation.


Guides
Reducér spildrisiko i laboratoriet
Læs mere
Der findes en række smarte produkter, der hjælper dig med at reducere spildrisikoen, især når det gælder prøvehåndtering, overførsel og opbevaring i laboratoriet.


Guides
Sådan vælger du den rigtige cellevækstflade
Læs mere
Vækstfladen på de produkter, du benytter under celledyrkning, er af afgørende betydning for en vellykket formering af celler. Er du i tvivl om, hvilken flade du bør vælge...


Guides
Sådan opfylder du UN3373-reglerne
Læs mere
Som afsender er et dit ansvar at opfylde UN3373-reglerne, når du sender diagnostiske prøver med posten. Hos Hounisen® hjælper vi dig gerne med at finde netop den forsende...


Guides
Guide til pålidelig prøveindsamling
Læs mere
Uanset opgaven kan SARSTEDT levere højkvalitetsudstyr til enkel, effektiv og sikker prøveindsamling.

Du kunne også være interesseret i...






